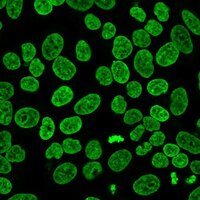

SCT120 Sigma-AldrichBioTracker 488 Green Nuclear Dye
Live cell imaging green nuclear staining dye with greater photostability than traditional blue fluorescent nuclear stains such as DAPI and Hoechst 33342.
More>> Live cell imaging green nuclear staining dye with greater photostability than traditional blue fluorescent nuclear stains such as DAPI and Hoechst 33342. Less<<Productos recomendados
Descripción
| Replacement Information |
|---|
| References |
|---|
| Biological Information |
|---|
| Physicochemical Information |
|---|
| Dimensions |
|---|
| Materials Information |
|---|
| Toxicological Information |
|---|
| Safety Information according to GHS |
|---|
| Safety Information |
|---|
| Packaging Information | |
|---|---|
| Material Size | 1 Kit |
| Transport Information |
|---|
| Supplemental Information |
|---|
| Specifications |
|---|
| Global Trade ITEM Number | |
|---|---|
| Número de referencia | GTIN |
| SCT120 | 04054839566943 |
Documentation
BioTracker 488 Green Nuclear Dye Certificados de análisis
| Cargo | Número de lote |
|---|---|
| BioTracker 488 Green Nuclear Dye | K1426985 |
| BioTracker 488 Green Nuclear Dye - K1430542 | K1430542 |
Ficha técnica
| Cargo |
|---|
| BioTracker¿ 488 Green Nuclear Dye |